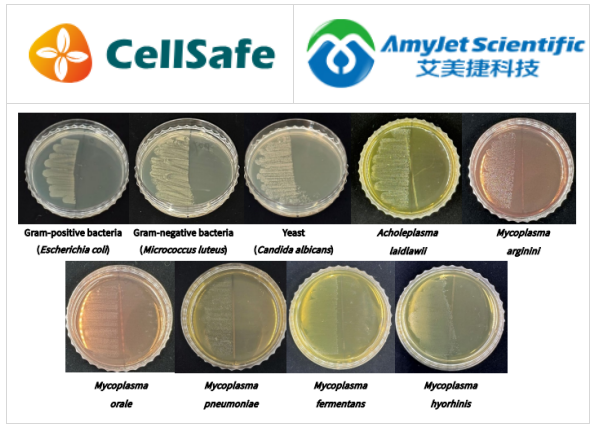
CellSafe

PRODUCT CENTER
特色產(chǎn)品當(dāng)前位置:首頁(yè) > 特色產(chǎn)品
當(dāng)細(xì)胞培養(yǎng)過(guò)程中發(fā)生支原體污染時(shí),可能會(huì)出現(xiàn)各種負(fù)面影響,包括細(xì)胞生長(zhǎng)緩慢以及細(xì)胞形態(tài)或功能的改變。這些變化會(huì)影響細(xì)胞的存活和功能,最終損害實(shí)驗(yàn)結(jié)果的準(zhǔn)確性。雖然支原體污染通常發(fā)生的概率較低,但一旦發(fā)生,它很容易在整個(gè)實(shí)驗(yàn)室的細(xì)胞培養(yǎng)系統(tǒng)中傳播。
污染主要?dú)w因于對(duì)實(shí)驗(yàn)設(shè)備、實(shí)驗(yàn)室臺(tái)面等處理的疏忽,這強(qiáng)調(diào)了管理實(shí)驗(yàn)室環(huán)境的重要性。因此,預(yù)防支原體污染的一個(gè)關(guān)鍵措施是定期清潔和消毒實(shí)驗(yàn)設(shè)備、儀器和實(shí)驗(yàn)室臺(tái)面。
CellSafe-BioMycoX?支原體預(yù)防噴霧是一種專(zhuān)門(mén)設(shè)計(jì)用于預(yù)防支原體的消毒劑。該產(chǎn)品在細(xì)胞培養(yǎng)過(guò)程中有效地預(yù)防支原體污染,并安全地保護(hù)細(xì)胞。
艾美捷CellSafe-BioMycoX支原體預(yù)防噴霧(#P-500, P-1000)特點(diǎn):
? BioMycoX支原體預(yù)防噴霧含有BioMyco-X,這是一種不僅能抑制支原體,還能抑制病毒、細(xì)菌、真菌和酵母的物質(zhì)。BioMyco-X是一種對(duì)人體健康安全的天然材料,允許安全地預(yù)防細(xì)胞系受到微生物污染。
? BioMycoX支原體預(yù)防噴霧含有酒精,通常適用于實(shí)驗(yàn)室中作為消毒劑或清潔劑。它出色的支原體抗菌特性使其在預(yù)防支原體污染方面非常有效。
? BioMycoX支原體預(yù)防噴霧可以用來(lái)消毒實(shí)驗(yàn)室設(shè)備的表面,包括潔凈工作臺(tái)、孵化器、工作臺(tái)、細(xì)胞儲(chǔ)存盒和液氮容器。
CellSafe-BioMycoX支原體預(yù)防噴霧使用說(shuō)明:
? 將支原體預(yù)防噴霧噴灑在實(shí)驗(yàn)室設(shè)備和儀器上,然后用紙巾擦拭干凈。
? 對(duì)于難以觸及的區(qū)域,將產(chǎn)品涂抹在紙巾上,用它來(lái)擦拭受污染的表面。
? 避免在對(duì)酒精敏感的設(shè)備或儀器上使用本產(chǎn)品,因?yàn)槠浜芯凭?/p>
使用注意事項(xiàng):
? 使用過(guò)程中避免與眼睛接觸。
? 使用手套、口罩、安全眼鏡或其他個(gè)人防護(hù)裝備。
? 僅供研究使用,不適用于醫(yī)療用途。
? 避免在封閉空間內(nèi)長(zhǎng)時(shí)間使用。
? 存放在通風(fēng)良好、涼爽的室溫環(huán)境中。
? 遠(yuǎn)離明火。
CellSafe-BioMycoX支原體預(yù)防噴霧抗菌測(cè)試:
為了測(cè)試BioMycoX?支原體預(yù)防噴霧不僅對(duì)六種支原體,還對(duì)細(xì)菌和酵母的抗菌效果,每種菌株都被涂布在固體培養(yǎng)基上。固體培養(yǎng)基的表面被分成兩半,噴霧只應(yīng)用于其中一半進(jìn)行培養(yǎng)。經(jīng)噴霧處理的部分沒(méi)有顯示出微生物生長(zhǎng),而未處理的部分則表現(xiàn)出旺盛的微生物生長(zhǎng)。這一觀(guān)察結(jié)果證實(shí)了BioMycoX?支原體預(yù)防噴霧的抗菌效力。
CellSafe致力于提供支原體全面解決方案,可以有效檢測(cè)、消除和預(yù)防影響細(xì)胞培養(yǎng)的支原體。作為CellSafe在中國(guó)區(qū)域的代理,艾美捷科技有限公司將為中國(guó)客戶(hù)提供全面的CellSafe產(chǎn)品。

微信掃碼在線(xiàn)客服